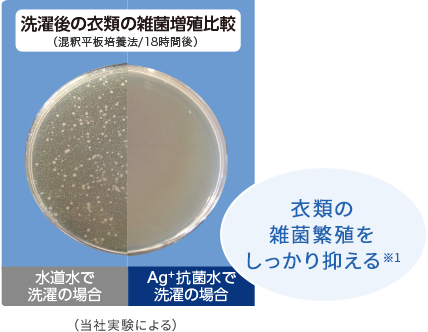

抗菌メガシャワー洗浄
DDモーターのパワフル水流で、ガンコな汚れをスッキリ落とす。
タテ型洗濯乾燥機(AW-8VM2)
メガシャワーで濃い洗剤液を、衣類全体に浸透させて
ザブーン水流で汚れを芯からキレイに!さらに抗菌※1
パワフルなシャワーで濃い洗剤液を、衣類のすみずみまで浸透させ、しっかり洗います。
パルセーターと直結したDDモーターで強力な立体水流をつくり出し、衣類の汚れを芯から落とします。
さらにAg+抗菌水でお洗濯のたびに衣類を抗菌し清潔に保ちます※1。


パルセーターの回転・反転速度を変えて、繊維の奥の汚れをもみ洗います。


衣類を引き込む水流と、押し上げる水流で、もみ出した汚れを押し出します。


小刻みに動かし、水流で衣類をほぐして広げ、汚れを落としやすくします。

東芝の洗浄力を支えるDDモーターは
強いパワーときめ細かいセンシングで、洗いから脱水までをコントロール
パワフル
- ● 勢いよく水を押し上げ強力なシャワーを生み出す
- ● パルセーターの回転力で大容量の衣類もしっかり動く
- ● パワフルなのに低騒音
かしこく洗う
- ● 衣類の量や質を見極め適切な水流をコントロール
- ● きめ細かい動きで衣類のからみや片寄りを防ぐ
- ● 高精度センサーで水位を細かく設定するから節水
パルセーター
ザブーンパル
パルセーターのカーブした羽根が、左右の回転によって異なる水流を生み、衣類を立体的に動かします。

Ag+抗菌水で洗うたびに抗菌
繊維の奥までしっかり抗菌※1、衣類を清潔に
水道水が抗菌水ユニットを通ることで、Ag+抗菌ビーズから銀イオンが溶け出し抗菌水に。洗濯水とともに繊維のすき間に入り込み、衣類にしっかり浸透します。お洗濯のたびに抗菌して、部屋干し臭などの元になる雑菌が衣類に繁殖するのを防ぎます。
洗濯水がAg+抗菌水ユニットを通過すると、銀イオンの抗菌成分が溶けてAg+抗菌水を生成します。
Ag+抗菌水ユニットは約10年間交換不要※2
交換が必要な場合は、東芝生活家電ご相談センターにお問い合わせください。

- ※1
抗菌について
- ●試験方法:JIS L1902に基づく菌液吸収法、当社にて処理した試験布を一般財団法人ボーケン品質評価機構にて評価
- ●抗菌方法:銀イオンによる
- ●対象部分:洗濯槽内の衣類
- ●試験結果:抗菌活性値2.0以上(菌の抑制率99%以上)
※2
年間洗濯回数600回にて計算。当社調べ
室温・水温、水道水圧、設置・排水条件、衣類の量や種類、衣類の片寄り、風呂水の使用などにより、使用水量・消費電力量・運転時間が増減します。
洗濯乾燥機につきましては、一般社団法人日本電機工業会・自主基準「乾燥性能評価方法(2009年11月19日改訂)」に基づき、表示を行っています。洗濯乾燥機とは洗濯から乾燥まで自動的に行い、乾燥容量が洗濯容量の半分以上のもので、乾燥性能が一般社団法人日本電機工業会で定めた基準を満足するものです。